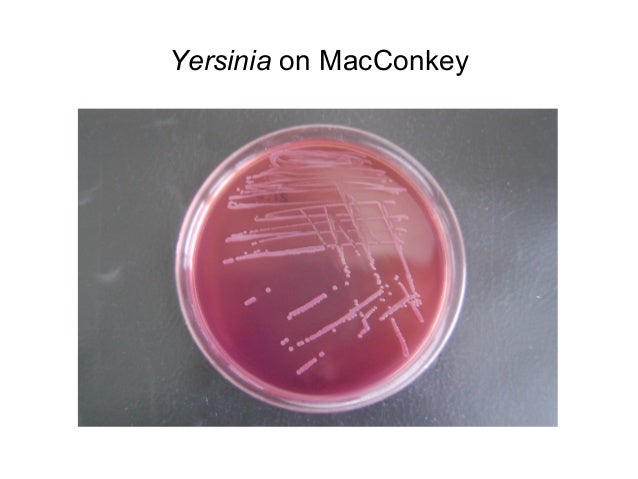

Xld Mac Download
XLD (X Lossless Decoder) is a tool for Mac OS X that is able to decode/convert/play various ‘lossless’ audio files. The supported audio files can be split into some tracks with cue sheet when decoding. It works on Mac OS X 10.4 and later.
Though, XLD should run natively on Intel Macs, PPC Macs, and the latest ARM Macs by using the Universal Binary, problems always occur when you are installing XLD, loading CD tracks or audio files, converting lossless audio on Mac Big Sur, Catalina, Sierra, EL Capitan, Yosemite and the eariler macOS.

How to install xld to mac free download. RaspEX Kodi RaspEX Kodi Build 210205, 210211 and 210208 with LXDE/LXQt/Kodi is made especially for the new Raspb. XLD (X Lossless Decoder) is a tool for Mac OS X that is able to decode/convert/play various ‘lossless’ audio files. The supported audio files can be split into some tracks with cue sheet when decoding. It works on Mac OS X 10.4 and later. Though, XLD should run natively on Intel Macs, PPC Macs, and. Read More ». Xld Mac Os X Download; Xld For Mac Os X Download; Xld For Mac Os X 10 11 Download Free; X Lossless Decoder v20191004 X Lossless Decoder (XLD) is a tool for OS X that is able to decode/convert/play various 'lossless' audio files. The supported audio files can be split into some tracks with cue sheet when decoding. XLD supports the following. X Lossless Decoder (XLD) is a tool for Mac OS X that is able to decode/convert/play various 'lossless' audio files. The supported audio files can be split into some tracks with cue sheet when decoding. It works on Mac OS X 10.4 and later. XLD is Universal Binary, so it runs natively on both Intel Macs and PPC Macs. Other formats supported.
What can we do when XLD for Mac won’t work?
When you are facing problems with XLD, no matter what the problems are, TechiSky recommends you that you download the latest version of XLD from the official site and try again. If problems still exist, you can download and try this smart XLD Alternative for Mac in the following.
Xld Download Mac
Introduces the smart XLD Alternative for Mac
Faasoft Audio Converter for Mac is a professional XLD alternative for Mac. It can batch convert among all sorts of normal and lossless audio formats including MP3, WMA, WAV, AAC, FLAC, OGG, APE, AIFF, SHN, TAK, Apple Lossless ALAC, extract audio from different format video and HD-video files (AVI, MPEG, WMV, MP4, FLV, MKV, H.264/MPEG-4 AVC, AVCHD).
The smart XLD alternative for Mac supports splitting audio files into tracks with the cue sheet while conversion. Moreover you can choose to convert an audio segment or several files at once, simultaneously output a file into several formats and to the required size, adjust conversion parameters, edit ID3 tag info, add various audio effects, along with a variety of other great features. Moreover, multithreading and multi-core CPU processing are supported for offering high speed conversion.

The wonderful XLD Replacementfor Mac is fully compatible with Mac OS X 10.4(Tiger), 10.5(Leopard), 10.6(Snow Leopard), 10.7(OS X Lion), 10.8(OS X Mountain Lion), 10.9(OS X Mavericks), 10.10(Yosemite), 10.11(EL Capitan), macOS 10.12 Sierra, 10.13 macOS High Sierra, 10.14 macOS Mojave, macOS Catalina, macOS Big Sur.
Guides on how to use XLD alternative for Mac to split tracks and convert audios?
Xld Mac Download Free
Download Faasoft Audio Converter. Install and launch the program. The following this guide to continuing conversion